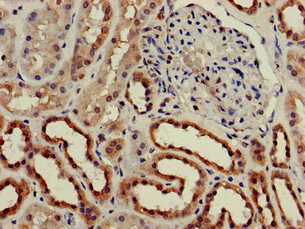

CH25H Antibody
-
中文名稱:CH25H兔多克隆抗體
-
貨號:CSB-PA005307LA01HU
-
規格:¥440
-
圖片:
-
其他:
產品詳情
-
產品描述:
CUSABIO uses the recombinant human CH25H protein (142-272AA) to immunize rabbits and then purify the rabbit antiserum through protein G to obtain the anti-CH25H antibody. This CH25H antibody is a polyclonal antibody and occurs as an unconjugated IgG. Its purity is greater than 95%. It only reacts with human CH25H protein, an IFN-induced enzyme that catalyzes the oxidation of cholesterol to 25-hydroxycholesterol (25HC) to reduce cholesterol accumulation. 25HC, a natural oxysterol, plays a role in regulating cholesterol homeostasis and sterol biosynthesis and exerts broad-spectrum antiviral function. And this anti-CH25H antibody can be used in ELISA and IHC for the detection of the CH25H protein.
-
產品名稱:Rabbit anti-Homo sapiens (Human) CH25H Polyclonal antibody
-
Uniprot No.:
-
基因名:
-
別名:CH25H; Cholesterol 25-hydroxylase; Cholesterol 25-monooxygenase; h25OH
-
宿主:Rabbit
-
反應種屬:Human
-
免疫原:Recombinant Human Cholesterol 25-hydroxylase protein (142-272AA)
-
免疫原種屬:Homo sapiens (Human)
-
標記方式:Non-conjugated
本頁面中的產品,CH25H Antibody (CSB-PA005307LA01HU),的標記方式是Non-conjugated。對于CH25H Antibody,我們還提供其他標記。見下表:
-
克隆類型:Polyclonal
-
抗體亞型:IgG
-
純化方式:>95%, Protein G purified
-
濃度:It differs from different batches. Please contact us to confirm it.
-
保存緩沖液:Preservative: 0.03% Proclin 300
Constituents: 50% Glycerol, 0.01M PBS, pH 7.4 -
產品提供形式:Liquid
-
應用范圍:ELISA, IHC
-
推薦稀釋比:
Application Recommended Dilution IHC 1:20-1:200 -
Protocols:
-
儲存條件:Upon receipt, store at -20°C or -80°C. Avoid repeated freeze.
-
貨期:Basically, we can dispatch the products out in 1-3 working days after receiving your orders. Delivery time maybe differs from different purchasing way or location, please kindly consult your local distributors for specific delivery time.
-
用途:For Research Use Only. Not for use in diagnostic or therapeutic procedures.
相關產品
靶點詳情
-
功能:Catalyzes the formation of 25-hydroxycholesterol from cholesterol, leading to repress cholesterol biosynthetic enzymes. Plays a key role in cell positioning and movement in lymphoid tissues: 25-hydroxycholesterol is an intermediate in biosynthesis of 7-alpha,25-dihydroxycholesterol (7-alpha,25-OHC), an oxysterol that acts as a ligand for the G protein-coupled receptor GPR183/EBI2, a chemotactic receptor for a number of lymphoid cells. May play an important role in regulating lipid metabolism by synthesizing a corepressor that blocks sterol regulatory element binding protein (SREBP) processing. As an interferon-stimulated gene, has broad antiviral activities against a wide range of enveloped viruses, such as vesicular stomatitis virus (VSV) and SARS coronavirus-2 (SARS-CoV-2). Its product, 25-hydroxycholesterol, activates the ER-localized enzyme ACAT to induce internalization of accessible cholesterol on the plasma membrane and restricts SARS-CoV-2 S protein-mediated fusion which inhibits virus replication. In testis, production of 25-hydroxycholesterol by macrophages plays a role in Leydig cell differentiation.
-
基因功能參考文獻:
- We examined whether 25HC restricts infection by mammalian reovirus. Results suggest that 25HC inhibits the efficiency of cellular entry of reovirus virions, which may require specific endosomal membrane dynamics for efficient membrane penetration. PMID: 29950420
- We detected Cholesterol 25-hydroxylase, the enzyme responsible for 25-HC production, in human spermatozoa at the level of the neck and the post acrosomal area. Upon incubation with spermatozoa, 25-HC induced calcium and cholesterol transients in connection with the acrosomal reaction. PMID: 27912195
- Exome analysis in 212 multiple sclerosis and 14 neuromyelitis optica patients identified a rare CH25H p.Q17H mutation in two NMO patients of Asian ancestry. In addition, association analysis of common CH25H variants. PMID: 26857497
- Infection with HCV causes up-regulation of interferon-inducible CH25H in vivo. PMID: 25999047
- These results demonstrate that CH25H constitutes a primary innate response against hepatitis C virus infection through regulating host lipid metabolism. PMID: 25903345
- Cholesterol 25-hydroxylase production by dendritic cells and macrophages is regulated by type I interferons. PMID: 20699362
- Based on the results of genome-wide screens, along with biological studies, we selected three genes as candidates for AD risk factors: ATP-binding cassette transporter A1 (ABCA1), cholesterol 25-hydroxylase (CH25H) and cholesterol 24-hydroxylase (CH24H). PMID: 16157450
顯示更多
收起更多
-
亞細胞定位:Endoplasmic reticulum membrane; Multi-pass membrane protein.
-
蛋白家族:Sterol desaturase family
-
數據庫鏈接:
Most popular with customers
-
-
YWHAB Recombinant Monoclonal Antibody
Applications: ELISA, WB, IHC, IF, FC
Species Reactivity: Human, Mouse, Rat
-
Phospho-YAP1 (S127) Recombinant Monoclonal Antibody
Applications: ELISA, WB, IHC
Species Reactivity: Human
-
-
-
-
-